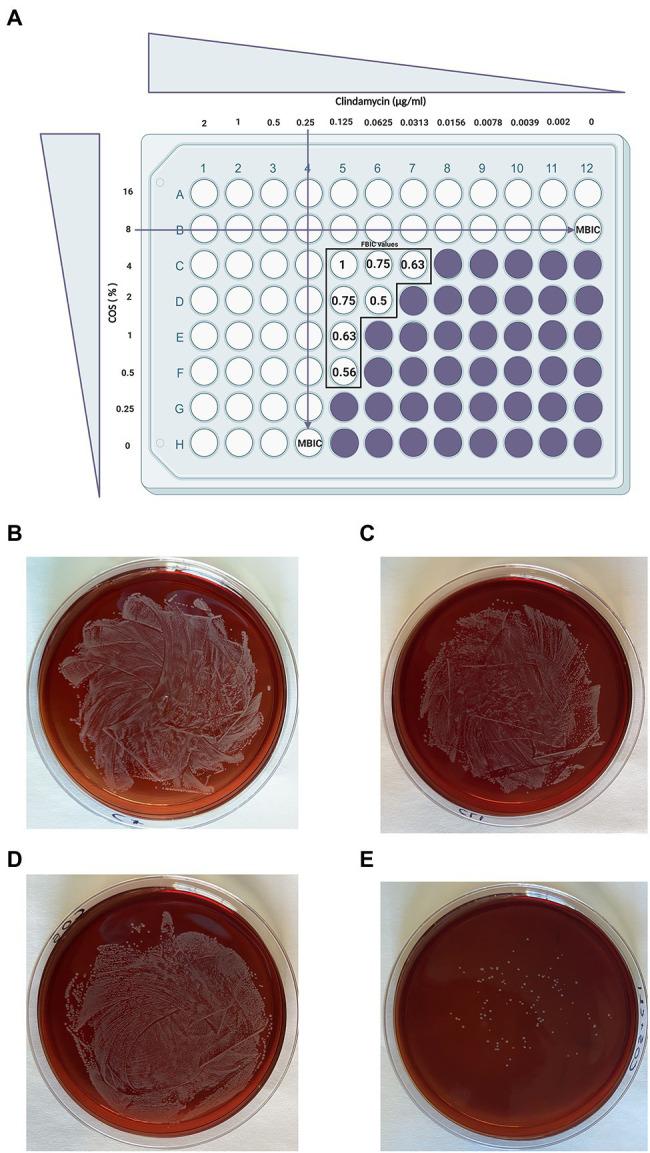
https://cdn.ncbi.nlm.nih.gov/pmc/blobs/5ca8/8473942/af53de505a2d/fmicb-12-700605-g005.jpg

海藻酸盐和壳寡糖对B组及……的抗菌活性 (原文此处不完整)
Antimicrobial Activities of Alginate and Chitosan Oligosaccharides Against and Group B .
作者信息
Asadpoor Mostafa, Ithakisiou Georgia-Nefeli, van Putten Jos P M, Pieters Roland J, Folkerts Gert, Braber Saskia
机构信息
Division of Pharmacology, Faculty of Science, Utrecht Institute for Pharmaceutical Sciences, Utrecht University, Utrecht, Netherlands.
Division of Infectious Diseases and Immunology, Department of Biomolecular Health Sciences, Faculty of Veterinary Medicine, Utrecht University, Utrecht, Netherlands.
出版信息
Front Microbiol. 2021 Sep 13;12:700605. doi: 10.3389/fmicb.2021.700605. eCollection 2021.
The bacterial pathogens (GBS) and () cause serious infections in humans and animals. The emergence of antibiotic-resistant isolates and bacterial biofilm formation entails the urge of novel treatment strategies. Recently, there is a profound scientific interest in the capabilities of non-digestible oligosaccharides as antimicrobial and anti-biofilm agents as well as adjuvants in antibiotic combination therapies. In this study, we investigated the potential of alginate oligosaccharides (AOS) and chitosan oligosaccharides (COS) as alternative for, or in combination with antibiotic treatment. AOS (2-16%) significantly decreased GBS V growth by determining the minimum inhibitory concentration. Both AOS (8 and 16%) and COS (2-16%) were able to prevent biofilm formation by wood 46. A checkerboard biofilm formation assay demonstrated a synergistic effect of COS and clindamycin on the biofilm formation, while AOS (2 and 4%) were found to sensitize GBS V to trimethoprim. In conclusion, AOS and COS affect the growth of GBS V and wood 46 and can function as anti-biofilm agents. The promising effects of AOS and COS in combination with different antibiotics may offer new opportunities to combat antimicrobial resistance.
细菌病原体(B组链球菌,即GBS)和(此处原文括号内容缺失)会在人类和动物身上引发严重感染。抗生素耐药菌株的出现以及细菌生物膜的形成促使人们迫切需要新的治疗策略。最近,不可消化的低聚糖作为抗菌、抗生物膜剂以及抗生素联合治疗中的佐剂的能力引起了广泛的科学关注。在本研究中,我们探究了海藻酸寡糖(AOS)和壳聚糖寡糖(COS)作为抗生素治疗的替代方案或与之联合使用的潜力。通过测定最低抑菌浓度发现,AOS(2%-16%)能显著降低B组链球菌V型(GBS V)的生长。AOS(8%和16%)以及COS(2%-16%)均能使生物膜形成减少46%。棋盘法生物膜形成试验表明,COS与克林霉素对生物膜形成具有协同作用,而AOS(2%和4%)能使GBS V对甲氧苄啶敏感。总之,AOS和COS会影响GBS V和(此处原文缺失相关内容)的生长,并可作为抗生物膜剂发挥作用。AOS和COS与不同抗生素联合使用的良好效果可能为对抗抗菌耐药性提供新的机遇。